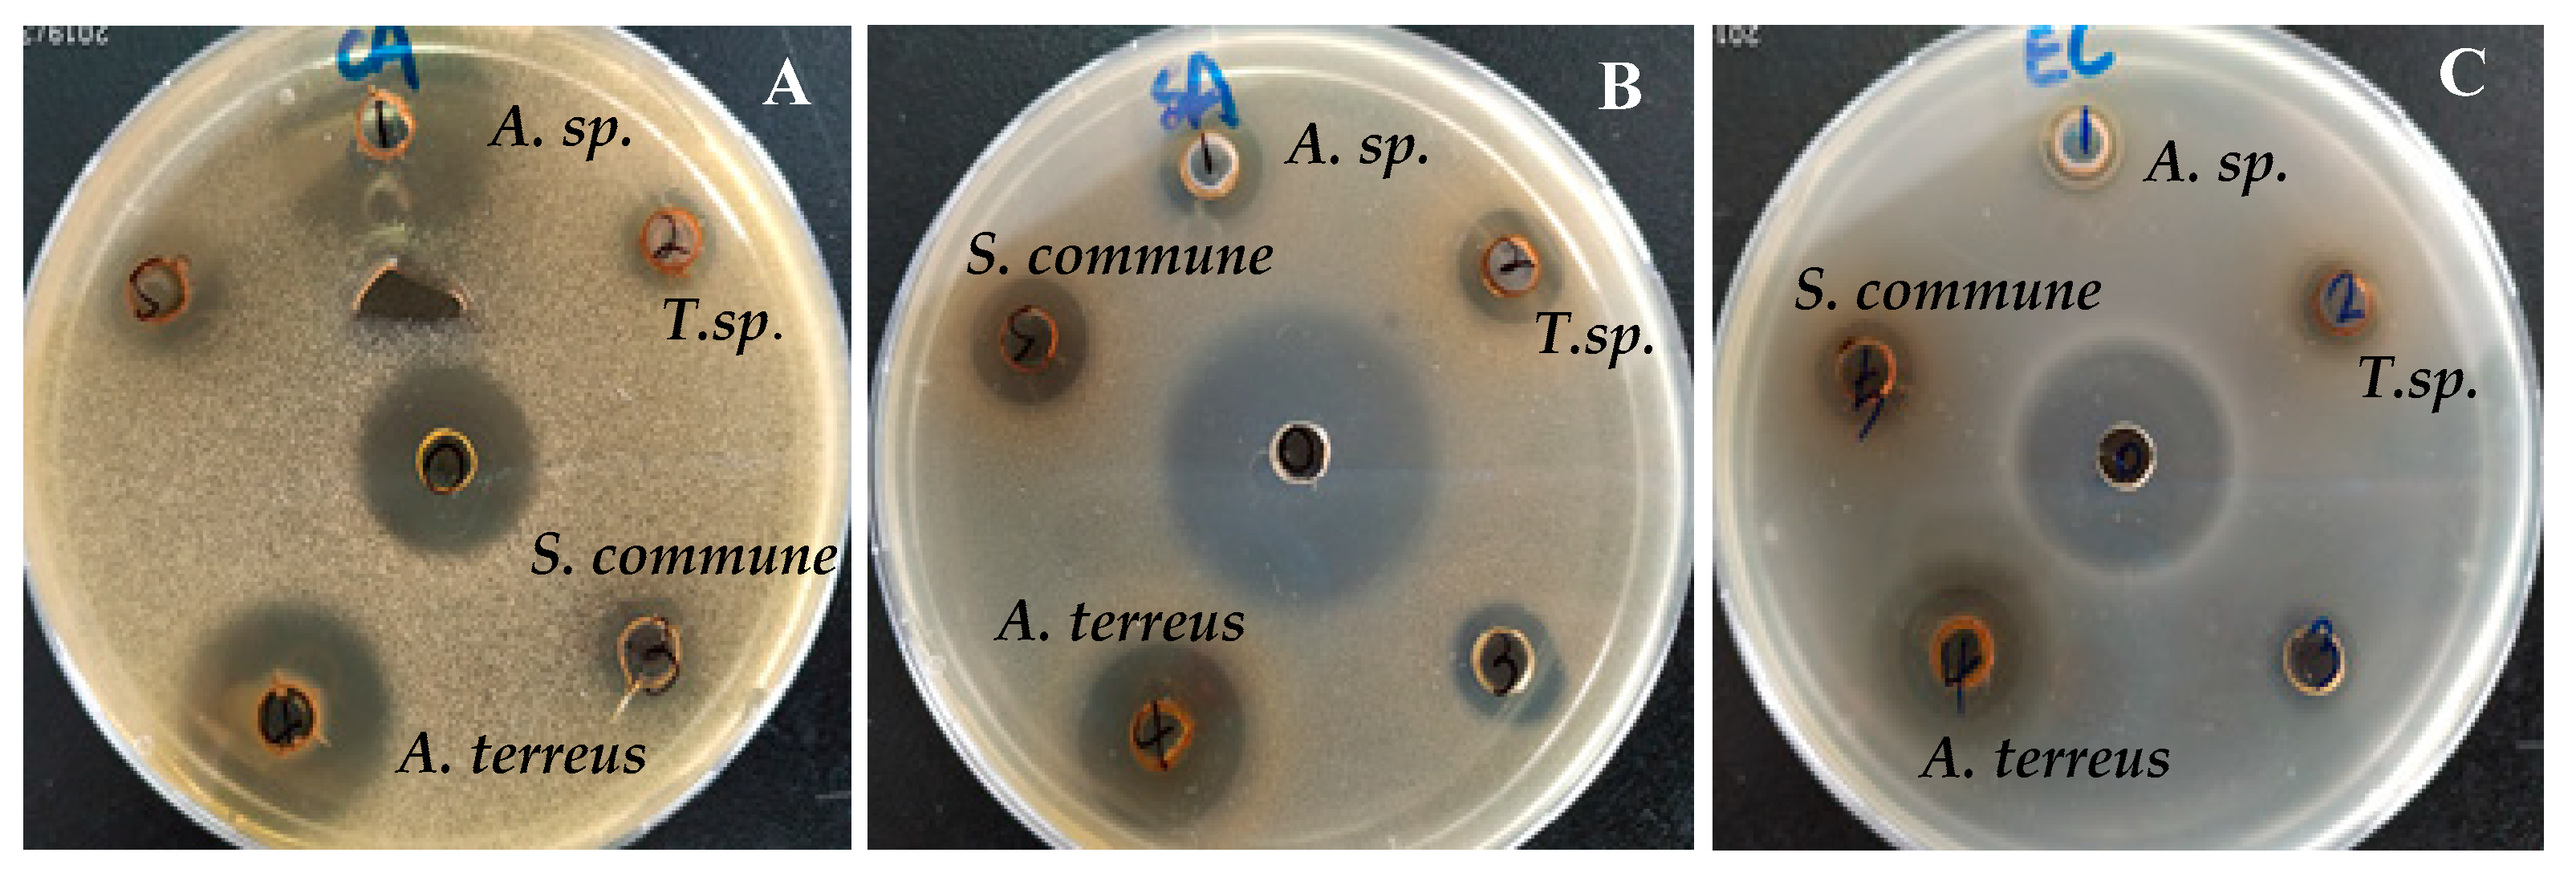
Microorganisms 08 00586 g002

Abstract
Endophytic fungi were first isolated from the fresh root of the Chinese medicinal plant Vernonia anthelmintica collected from the Hotan Prefecture within the Xinjiang Autonomous region of the People’s Republic of China. This plant has been used in Uyghur traditional medicine to treat vitiligo, a skin condition characterized by patches of the skin losing their pigment. In total, fifteen fungal strains were isolated. Among these, four endophytic fungi were identified by their DNA sequences and registered to GenBank with accession numbers. The isolates were identified as Schizophyllum commune XJA1, Talaromyces sp. XJA4, Aspergillus sp. XJA6, Aspergillus terreus XJA8. Ethyl acetate extracts of all fungal strains were used to quantify melanin content and to identify in vitro biological activity assays including antimicrobial, antioxidant, cytotoxic, antidiabetic and tyrosinase activity on B16 cells. Among the extracts of all four identified strains, the ethyl acetate extract of the Aspergillus sp. XJA6 was chosen for further characterization because it presented the highest biological activity against these tests. In addition, twenty four volatile compounds from the petroleum ether fraction were characterized by GC–MS.
1. Introduction
Plant endophytic microorganisms are symbiotic and live inside plants, and are further defined as bacteria, fungi, or viruses that spend all or part of their life cycle residing intercellularly/intracellularly within the host plant without causing overt negative effects [1,2]. Recent studies have isolated and identified endophytic microorganisms and the biologically active compounds they produce. Endophytic fungi, in particular, are a pivotal source of biologically active secondary metabolites [3]. Usually, secondary metabolites synthesized by endophytes are highly regulated and modulated at the genetic level; however, when the external environment is physiologically affected, these genes are further activated in response [4]. In addition, these compounds support the growth of host plants by increasing the resistance to external biotic and abiotic factors, and by enhancing resistance to insects and plant pathogens [5,6]. Many metabolites exhibit a range of biological activities and are important drivers of pharmaceutical innovation and discovery. Biologically active secondary metabolites include terpenoids [4,7], alkaloids [8], steroids [9], polyketides, quinones, lignans, and phenols [10]. These display various biological activities such as [9] antimalarial, anti-tubercular, antibacterial, antidiabetic [11], cytotoxicity [12], antioxidant [13], and acetylcholinesterase inhibition [14]. For example, secondary metabolites isolated from the fungus Aspergillus niger show moderate to strong antimicrobial activity against different test pathogens. [15]. Likewise, derived secondary metabolites from the fungus Aspergillus flavipes Y-62 displayed antimicrobial activity against the Gram-negative pathogens Pseudomonas aeruginosa and Klebsiella pneumoniae with equal minimum inhibitory concentrations (MICs) [2]. Xiao et al. [16] isolated compounds from the endophytic fungus Aspergillus sp. that are cytotoxic against the A549 cell line. The endophytic fungus Aspergillus tamarii from the roots of Ficus carica formed secondary metabolites with potential cytotoxic activity against human cancer cells such as MCF-7 and A549 [17]. Other natural products were isolated from a culture of the endophytic fungus Diaporthe sp. and displayed significant antioxidant activity [17]. Chemical constituents of the mangrove-derived fungus Aspergillus sp. were studied by Elissawy et al. [18] who identified the antiproliferative and very high cytotoxic activity of the produced natural compounds using Caco-2 cell lines.
The medicinal plant V. anthelmintica belongs to the Asteraceae family. Recently, several chemical components were isolated from the seeds of V. anthelmintica and have demonstrated relevant biological activities, in particular with respect to the traditional Chinese medicinal use of the plant as a vermicide [19], as well as for treating skin diseases, including vitiligo, in traditional Uyghur medicine. These components define the main medicinal material in most preparations for treatment of vitiligo. Additional natural products isolated from seeds of V. anthelmintica include flavonoids [20,21], terpenoids, phenolic compounds and steroids [22]. However, constituents effective in treating vitiligo were not characterized. Therefore, we have isolated and systematically studied endophytic fungi from the root of the medicinal plant V. anthelmintica (Figure 1) growing in China. Fungal strains were cultured on a potato dextrose broth (PDB) medium. The culture was extracted with ethyl acetate to form crude extracts which were then tested for antimicrobial, cytotoxic, antioxidant, and antidiabetic activities, as well as screened for effects on melanin synthesis in murine B16 cells for vitiligo treatment.
Figure 1.
Main approach used in the present study.
2. Materials and Methods
2.1. Plant Collection
The Chinese traditional medicinal plant V. anthelmintica was collected from Hotan, within the Xinjiang Autonomous region, in October 2018. The fresh root of the plant was transported to the laboratory of Xinjiang Indigenous Medicinal Plants Resource Utilization, Xinjiang Technical Institute of Physics and Chemistry, Chinese Academy of Sciences.
2.2. Isolation and Identification of Endophytic Fungi
The root systems were separated from the plant and the roots washed thoroughly with water [23]. The roots were then washed in sterile distilled water six times, soaked for 1–2 min in 70% ethanol followed by 5.25% sodium hypochlorite for 2–5 min, and again in 70% ethanol for 30–60 seconds before washing in distilled water. In order to obtain a root liquid, 2 g of root was crushed, 2–3 mL of sterile distilled water was added and the solution incubated for about 3 min. A total of 100 µL of root liquid was spread on sterile potato dextrose agar (PDA) medium containing chloramphenicol (100 μg/mL) as an antibacterial agent [19]. The PDA medium consisted of potato extract (4 g/L), dextrose (20 g/L), and agar (15 g/L) at pH 6.0. The medium was sterilized by autoclaving at 120 °C for 20 min. The fungal strains in the petri dishes were incubated at 28 °C for 7–10 days. After incubation, colonies with a different color, shape, and consistency were streaked on PDA plates and incubated for one week to ensure the purity of the isolates. Homogenous colonies of different colors, shapes, and sizes were used for DNA isolation [24]. Endophytic fungi were identified by their DNA gene sequences.
2.3. Fermentation Medium
The endophytic fungi were cultivated in one liter of PDB liquid medium (dextrose 20 g/L, potato extract 4 g/L) and incubated at 28 °C on a shaker at 160 rpm for four weeks [24]. The culture was then filtered by vacuum filtration. Afterwards the culture filtrate was extracted with ethyl acetate (2 × 300 mL) in a separatory funnel (solvent–solvent extraction) [25]. The ethyl acetate extract was concentrated on a rotary evaporator. The crude extracts were dissolved in dimethyl sulfoxide (DMSO) and evaluated for their biological activities.
2.4. Antimicrobial Assay
The three pathogenic microorganisms used for the antimicrobial assays were the Gram-positive bacterium Staphylococcus aureus (ATCC6538), the Gram-negative bacterium Escherichia coli (ATCC11229) and the fungus Candida albicans (ATCC10231) [26]. The bacterial strains were plated on LB medium (4% glucose, 1% peptone) and the fungus in potato dextrose agar (PDA) (4 g potato extract, 20 g dextrose, agar 20 g, and 1 L water) by the well diffusion method, and incubated at 28 °C for 48 h in accordance with Santos et al. [24]. A total of 6 µL of cell-free suspension from endophytic fungi was added to these wells, and the plates were incubated at 37 °C for 24 h for the bacterial strains and 72 h for the fungus. Diameters of the microbial growth inhibition zones were measured to assess the antimicrobial activity of the samples. Ampicillin was obtained from Sigma Chemicals Co., and Amphotericin B. was purchased from AMRESCO LLC.
2.5. Melanin Content Assay
2.5.1. Cell Culture
Murine B16 melanoma cell lines (B16F10) were obtained from CAS (Chinese Academy of Sciences, China). Cells were cultured in Dulbecco’s modified Eagle medium (DMEM, Gibco Life Technologies, Waltham, MA, USA) supplemented with 10% heat-inactivated fetal bovine serum (FBS), penicillin G (100 U/mL), and streptomycin (100 mg/mL) (Gibco-BRL, Grand Island, NY, USA) at 37 °C in a humidified atmosphere of 5% CO2.
2.5.2. Melanin Measurement
The melanin content was determined in accordance with the procedure described previously [27,28,29,30]. B16 cells were seeded in a six-well plate at a concentration of 2 × 105 cells per well and incubated for 24 h. The cultured B16 cells were further incubated in the absence or the presence of the sample for 48 h. Each well with cells was then washed twice with ice-cold PBS. Cells were then lysed as described previously [28]. A total of 150 µL aliquots of each lysate were put in a 96-well microplate and absorbance was read spectrophotometrically at 405 nm using a multi-plate reader. The protein content of each sample was determined by a BCA Protein Assay Kit (Biomed, Beijing, China). The melanin content was normalized to the cellular protein concentration. Melanin content was calculated according to Formula (1):
where S is the absorbance of the cells treated by the samples and B is the absorbance of the wells containing untreated cells. Each measurement was carried out in triplicate.
2.5.3. Tyrosinase Activity Assay
Tyrosinase activity was performed using the method of Chao et al. [31]. First, the B16 cells were seeded in a six-well plate at a concentration of 2 × 105 cells per well and incubated for 24 h. Test samples were then added to each well and incubated for 24 h. Cells were then washed twice with ice-cold PBS and lysed using 1% Triton X-100 solution containing 1% sodium deoxycholate for 30 min at −80 °C. The lysates were centrifuged at 12,000× g for 15 min. After quantification and adjustment of the protein concentration of the supernatants, 90 µL of supernatant was mixed and incubated with 10 µL of freshly prepared substrate solution (10 mM L-DOPA) in duplicate in a 96-well plate followed by incubation at 37 °C. Samples were then read at 490 nm. Results were calculated by the formula used for the calculation of melanin content.
2.6. Protein Tyrosine Phosphatase 1B (PTP1B) Inhibition Assay
The PTP1B Inhibitor was purchased from Merck specialties private limited. The PTP1B inhibitory activity of the cell-free supernatant of the endophytic fungal extract was carried out using p-nitrophenyl phosphate disodium salt (pNPP) as the substrate [32]. The crude extract of the fungal strains was dissolved in 50 mg/mL DMSO and pre-treated with the enzyme at room temperature for 5 min. One µL of a 0.115 mg/mL PTP1B protein solution was added to 178 µL of a solution of 20 mM HEPES buffer, 150 mM NaCl and 1 mM EDTA. The test and positive control samples were then added at a volume of 1 µL followed by addition of 20 µL of 35 mM substrate. The solution was mixed for 10 min. The plate was incubated in the dark for 30 min and the reaction terminated by addition of 10 µL of 3 M NaOH solution. The absorbance of the plate was read at 405 nm. The blank sample did not contain the enzyme. SpectraMax MD5 (USA Molecular Devices) was used to read the absorption of the plates. The inhibition rate (IR) of PTP1B by the samples was calculated using Formula (2):
where PC is the absorbance of the control and PS is the absorbance of the sample.
2.7. Cytotoxic Activity (MTT Assay)
The [3-(4,5-dimethylthiazolyl)-diphenyl tetrazolium bromide] (MTT) assay was performed using the method of Bozorov et al. [33,34,35]. A stock solution of ethyl acetate extract of the fungus solution was prepared in 50 mg/mL DMSO. The anticancer assay was performed using MDA-MB-231 (breast cancer), Hela (cervical cancer), and HT-29 (colon cancer) cells. The positive control doxorubicin (DOX) was purchased from BBI Inc. (Shanghai, China), and the human cancer cell breast (MDA-MB-231), cervical (Hela), colon (HT-29) and human embryonic kidney (HEK-293) lines were obtained from Chinese Type Culture Collection, CAS (Shanghai, China). The cancer cell lines were separately seeded in 96-well plates at a density of 3–103 cells per well followed by 24 h incubation at 37 °C, 95% humidity, and 5% CO2. After incubation, the cells were treated with 30 µM of test samples (crude extracts) and left for 48 h. Twenty µL of 5 mg/mL MTT was then added to each well and the plates were incubated at 37 °C for 4 h. Absorbance was read at 540 nm after removal of the supernatant and the addition of 200 µL DMSO to each well and the shaking of the multiwall plates for 10 min to completely dissolve the secondary metabolites. The inhibition rate was determined by Formula (3):
where C is the OD of the control group, S is the OD of the experimental group, and B is the OD of the blank.
2.8. DPPH Radical Scavenging Activity Assay
The 2,2′-diphenyl-1-picrylhydrazyl (DPPH) test was carried out using the method of Rehebati et al. [36]. A 100-μL sample (concentration 50 mg/mL) was mixed with 100 μL of a freshly prepared 0.2 mM DPPH solution in each well of a 96-well microplate. The microplate was kept in the dark for 30 min at room temperature. The absorbance was recorded at 517 nm, and the inhibition rate was calculated. Vitamin C was used as a positive control. The inhibition rate (IR) of the positive control and samples was calculated using the following formula:
where A0 is the absorbance of the blank and A1 is the absorbance of the test sample.
2.9. Gas Chromatography–Mass Spectrometry (GC–MS) Analysis
Gas Chromatography–Mass Spectrometry GC–MS analyses were conducted using the Agilent 6890 gas chromatograph-assisted Agilent 5973 mass detector (Agilent Technologies, USA). A capillary column (30 m × 0.25 mm internal diameter; CM Scientific, USA), coated with a 0.25-µM film of 5% (v/v) phenyl methyl siloxane, was used for separation. The oven temperature was set at 100 °C and held for 5 min, then increased to 145 °C at a rate of 5 °C/min, and held at this temperature for 25 min. The inlet temperature was 250 °C and the ionization source temperature was 280 °C. Data handling was performed using the Agilent ChemStation software (Agilent Technologies, USA) [37]. The compounds were identified on the basis of retention indices (RI) and by comparing the spectra with a stored MS library (W8N05ST and NIST08).
2.10. Statistical Analysis
Data were analyzed using GraphPad Prism using three replicate values in a side-by-side subcolumn analysis of variance (ANOVA), and Tukey’s test to determine statistical significance. A p-value of <0.05 was considered to be statistically significant. The correlation index was calculated using the Pearson coefficient (ρ).
3. Results and Discussion
3.1. Isolation and Identification of Endophytic Fungi
Fifteen fungal strains were isolated from the fresh roots of the medicinal plant V. anthelmintica. All isolated fungal strains were cultivated by PDB medium and extracted with ethyl acetate to produce crude extracts. Among these, only four crude extracts of the endophytic fungi (S. commune XJA1, Talaromyces sp. XJA4, Aspergillus sp. XJA6, and A. terreus XJA8) were selected for our study. The primary screening of these crude extracts showed satisfactory antimicrobial activity. All fungal strains were identified by DNA sequencing and registered in GenBank (accession numbers MK736352, MK736671, MK748459, and MK748458; www.ncbi.nlm.nih.gov). The respective isolates showed 98%–99.79% homology to S. commune XJA1, Talaromyces sp. XJA4, Aspergillus sp. XJA6, and A. terreus XJA8. Two isolates belong to the genus Aspergillus.
3.2. Chemical Composition of the Endophyic Fungus Aspergillus sp. XJA6 Extract by GC–MS
The primary biological screening revealed that the endophytic strains S. commune XJA1, Talaromyces sp. XJA4, Aspergillus sp. XJA6, and A. terreus XJA8 displayed antimicrobial activity, with Aspergillus sp. XJA6 exhibiting the highest activity. In addition, the volatile chemical composition of the Aspergillus sp. XJA6 extract was studied by GC–MS analysis. The volatile compounds of petroleum ether (1.D) and petroleum ether–ethyl acetate fractions at a ratio 80:1 (2.D) from Aspergillus sp. XJA6 crude extract were separated using column chromatography. This analysis revealed thirteen components in the 1.D fraction (Table 1), the major components being dibutyl phthalate (46.57%), bis (2-ethylhexyl) phthalate (14.85%), diisobutyl phthalate (5.98%), and bis (2-ethylhexyl) adipate (4.21%). In addition, eleven components were found in the 2.D fraction (Table 2) with the principal components being undecanoic acid (27.33%), palmitic acid (11.63%), stearic acid (5.31%) and di-sec-butyl phthalate (3.55%). It is notable that some volatile components were found in both fractions. Although compounds such as di-sec-butyl phthalate, methyl 14-methylhexadecanoate, bis (2-ethylhexyl) phthalate, and methyl 12-methyltetradecanoate were found in the both fractions, the amounts of these components differed between fractions 1.D and 2.D.
Table 1.
The chemical composition of petroleum ether (1.D).
Table 2.
The chemical composition of petroleum ether–ethyl acetate (2.D).
3.3. Antimicrobial Activity of Endophytic Fungi
A part of the present study focused on the systematic screening of crude extracts from endophytic fungi. The aerial parts of the V. anthelmintica are understood to have potential as adjuncts to the antimicrobial arsenal in herbal medicine. Isolated secondary metabolites from this medicinal plant showed promising antibacterial activities against several pathogenic microorganisms [38,39]. Our work is the first study of antimicrobial inhibition of extracts from endophytic fungi of the V. anthelmintica plant, and we have also studied extracts of the poorly characterized V. anthelmintica root. In this regard, we provide here the antimicrobial properties of the selected endophytic strains of S. commune XJA1, Talaromyces sp. XJA4, Aspergillus sp. XJA6, and A. terreus XJA8. The antimicrobial properties of the fungal crude extracts were estimated using three pathogenic microbes, S. aureus (ATCC6538) (Gram-positive bacteria), E. coli (ATCC11229) (Gram-negative bacteria) and C. albicans (ATCC10231) (fungi) (Table 3). The crude extract of Aspergillus sp. XJA6 (ethyl acetate extract derived from the filtrate of PDB culture) exhibited strong (23 mm zone of inhibition (ZOI)) antifungal activity against the C. albicans strain, as well as moderateantibacterial inhibition (11 and 8 mm ZOI) of S. aureus and E. coli strains. Extracts of A. terreus XJA8 showed greater antifungal activity to C. albicans (20 mm ZOI) and antibacterial activity against S. aureus and E. coli, with inhibition zones of 16 and 12 mm, respectively. The crude extracts of S. commune and Talaromyces sp. XJA4 showed moderate growth inhibition against S. aureus, E. coli, and C. albicans (12, 9.5, 11 mm, and 11, 9, 9 mm ZOI, respectively).
Table 3.
Antimicrobial activity of fungal endophytes from V. anthelmintica against some pathogenic bacteria and fungi.
Among the prepared crude extracts of the endophytic strains, A. terreus XJA8 exhibited significant inhibition zones for all pathogenic microorganisms, while Aspergillus sp. XJA6 extract displayed significant antifungal activity against C. albicans (Figure 2). These observations confirm the antimicrobial behavior of the Aspergillus species. Previously, the antimicrobial activity of the endophytic fungal strain Aspergillus sp. ASCLA from leaf tissues of the medicinal plant Callistemon subulatus was investigated against S. aureus, Pseudomonas aeruginosa, C. albicans, and Saccharomyces cerevisiae and exhibited moderate to high activity [40]. In our case the Aspergillus strain was isolated from the root of this herbal plant.
Figure 2.
Antimicrobial activity of fungal endophytes from V. anthelmintica against some pathogenic fungus C. albicans (A) and bacteria S. aureus (B) and E. coli (C).
As noted above, natural compounds isolated from V. anthelmintica exerted antibacterial properties against various pathogenic microbial strains. Steroid derivatives obtained from V. anthelmintica, for example, exhibited antibacterial activities against B. cereus, S. aureus, B. subtilis and E. coli, with MICs ranging from 3.15 to 15.5 μg/mL [38]. Ethyl acetate extracts studied in the present work possibly contain secondary metabolites such as steroids, terpenes or terpenoids, which may be responsible for the antimicrobial activities.
3.4. Effect of Crude Extracts of Endophytic Fungi Derived from V. anthelmintica Root on Melanin Content Assay and Tyrosinase Activity in B16 cells
It was previously reported that secondary metabolites from the seeds of V. anthelmintica demonstrated effects on melanin synthesis in B16 melanoma cells [20]. Recently we isolated the entophytic bacterium Pantoea ananatis obtained from V. anthelmintica root. The crude extracts of the ethyl acetate fraction formed by P. ananatis influenced melanin synthesis in murine B16 cells [27]. Moreover, seven alkaloids such as 1H-indol-7-ol, tryptophol, 3-indolepropionic acid, tryptophan, 3,3-di(1H-indol-3-yl)propane-1,2-diol, cyclo(L-Pro-L-Tyr) and cyclo[L-(4-hydroxyprolinyl)-L-leucine, along with one dihydrocinnamic acid were also derived from the entophytic bacterium P. ananatis crude extract. Note also that the secondary metabolite cyclo(L-Pro-L-Tyr) showed the strongest effect on melanin synthesis in murine B16 cells [27]. Continuing our previous research on endophytes of V. anthelmintica root, we have now investigated the effect of the selected crude extracts (S. commune XJA1, Talaromyces sp. XJA4, Aspergillus sp. XJA6, and A. terreus XJA8) of endophytic fungi produced from V. anthelmintica root on melanin synthesis in murine B16 cells. The crude extracts of endophytic fungi were evaluated for their effects on the synthesis of melanin pigments and intracellular tyrosinase activity in B16 cells. This method was carried out as described by Niu et al. [31] and Rustamova et al. [27]. After 48 h of treatment with crude extracts at 50 µg/mL, melanin content in B16 cells was determined (Figure 3).
Figure 3.
Effect of secondary metabolites of endophytic fungi on melanin production in B16 cells, (** p value ˂ 0.01, while **** p values ˂ 0.0001, compared with the dimethyl sulfoxide (DMSO)-treated control).
The crude extract of the ethyl acetate fraction from endophytic fungi increased melanin synthesis in murine B16 cells in a dose-dependent manner, and this activity was comparable to that of the reference drug 8-methoxypsoralen (8-MOP) [30]. The crude extracts of fungal strains A. terreus XJA8 and Aspergillus sp. XJA6 strongly increased melanin synthesis by 177.92% and 182.45% at 50 µg/mL, while 8-MOP increased synthesis by only 133.34%. The crude extracts of Talaromyces sp. XJA4 (50 µg/mL, 118.16%) and S. commune XJA1 (50 µg/mL, 119.02%) demonstrated a similar influence on melanin synthesis in B16 cells. The crude extracts of A. terreus XJA8 and Aspergillus sp. XJA6 were selected for further investigation due to their strong melanin synthesis and tyrosinase activity in murine B16 cells (Figure 3). Strains A. terreus XJA8 (1 µg/mL, 95.58%; 10 µg/mL, 102.07% and 50 µg/mL, 165.46%), and Aspergillus sp. XJA6 (1 µg/mL, 92.86%; 10 µg/mL, 131.64% and 50 µg/mL, 183.32%; 8-MOP 50 µg/mL, 142.86%) also increased melanin synthesis in a dose-dependent manner. The tyrosinase activities of these strains in B16 cells were also determined, and treatment of ethyl acetate crude extracts exhibited a similarly increased response (Figure 4). Treatment with the selected crude extracts of endophytic fungi at concentrations from 1 to 50 µg/mL resulted in intensified intracellular tyrosinase activity (Aspergillus sp. XJA6, 1 µg/mL, 131.49%; 10 µg/mL, 125.22%; 50 µg/mL, 159.94%; 8-MOP 50 µM, 133.25%). The crude extracts were tested on melanin synthesis in murine B16 cells, and synergistic effects (effects of non-isolated secondary metabolites in the crude extract) showed that secondary metabolites influenced the activity on melanin synthesis compared to that of 8-MOP. Further separation and purification of the compounds is needed to determine which secondary metabolites (in crude extracts) influence activity, and our laboratory is actively pursuing these. Terpenes isolated from the seeds of V. anthelmintica showed melanin production in B16 cells [41].
Figure 4.
Stimulation of melanin content assay (A,B) and tyrosinase activity of B16 cells (C,D) by fungal strain crude extracts at different concentrations of Aspergillus sp. XJA6 and A. terreus XJA8. (All **** p values for melanin content and tyrosinase activity are ≤0.0001, compared with the DMSO-treated control. All * p-values for tyrosinase activity are ˂0.05, while ** p-values for tyrosinase activity are ˂0.01, compared with the DMSO-treated control).
3.5. Antidiabetic Activity (PTP1B Assay)
PTP1B plays an important role in the negative regulation of insulin signaling. Crude extracts of the endophytes and plants or their derived secondary metabolites inhibited PTP1B activity [42,43,44]. Crude extracts of the endophytic strains have not been sufficiently explored with regard to PTP1B inhibition activity, active secondary metabolites produced by endophytic fungi, or identification of bacterial strains exhibiting PTP1B activity. For example, novel guignardins isolated from cultures of the endophytic fungus Guignardia sp. KcF8, itself from the mangrove Kandelia candel, have been presented a new class of PTP1B inhibitors [45]. In 2019, Gao et al. reported PTP1B inhibitory activity from a new polyketide compound isolated from cultures of the endophytic fungus Pestalotiopsis neglecta [46]. In our study, we also investigated PTP1B inhibitory activity of crude extracts from S. commune XJA1, Talaromyces sp. XJA4, Aspergillus sp. XJA6, and A. terreus XJA8. The extracts were screened in vitro for antidiabetic activity by PTP1B enzyme inhibition assay. The crude extracts of Aspergillus sp. XJA6 and Talaromyces sp. XJA4 exhibited significant inhibition of PTP1B with IC50 values of 5.662 ± 1.099 μg/mL and 4.789 ± 1.222 μg/mL. In addition, crude extracts of the endophytic fungi A. terreus XJA8 and S. commune XJA1 moderately inhibited PTP1B (IC50 23.439 ± 0.734 μg/mL and 11.964±0.484 μg/mL, Table 4). Note, however, that the crude extract of A. terreus XJA8 had only a modest influence on PTP1B enzyme inhibition, although this crude extract was more effective in the bioassays described above (antimicrobial and melanin synthesis in murine B16 cells). These observations and synergistic aspects of the crude extract components suggest that isolation of the appropriate secondary metabolites obviates the need to test PTP1B enzyme inhibition activity.
Table 4.
Antidiabetic activities of ethyl acetate crude extracts of selected endophytic fungi.
3.6. Cytotoxic Activity of Ethyl Acetate Extracts Obtained from Fungal Endophytes
Literature reviews suggest that endophytic fungi and their derived secondary metabolites exhibit potential activity against specific cancer cell lines [47]. Anticancer properties are generally associated with the cytotoxicity of the secondary metabolites present in the endophytic fungi [48]. Many endophytic strains synthesizing anticancer agents were classified taxonomically and species of the genus Aspergillus were found to produce anticancer compounds [48,49]. In our case, among the four selected crude extracts of the endophytic fungi (S. commune XJA1, Talaromyces sp. XJA4, Aspergillus sp. XJA6, and A. terreus XJA8), two species are members of the Aspergillus genus. The MTT assay was used to assess the cytotoxic activity of these samples. Crude extract of fungi were measured against the following human cancer cell lines: HT-29 (colon cancer), MDA-MB-231 (breast cancer), and Hela (cervical cancer) (Table 5). The reference drug DOX was used as positive control. When tested on Hela and HT-29 lines, the ethyl acetate crude extracts of endophytic fungi Aspergillus sp. XJA6 and A. terreus XJA8 showed strong activity with IC50 values of 9.99 ± 0.8 μg/mL and 5.73 ± 0.6 μg/mL. IC50 values of extracts of Aspergillus sp. XJA6 and Talaromyces sp. XJA4 against the HT-29 cell line were 19.31 ± 0.8 μg/mL and 90.43 ± 0.01 μg/mL. Only the crude extract of S. commune XJA1 displayed no activity. When screened on breast cancer cells, extracts of Aspergillus sp. XJA6 and A. terreus XJA8 strain showed moderate activity (IC50 33.55 ± 0.1 μg/mL and 56.3 ± 0.6 μg/mL). Crude extracts of A. terreus XJA8, Talaromyces sp. XJA4 and S. commune XJA1 IC50 activities on Hela cells were 24.69 ± 0.2.85 μg/mL, 46 ± 0.3 μg/mL and 89.8 ± 0.4 μg/mL, respectively.
Table 5.
Cytotoxic activity of ethyl acetate extracts obtained from fungal endophytes on human cancer cell lines HT-29, MDA-MB-231 and Hela.
Crude extracts of Aspergillus sp. XJA6 and A. terreus XJA8, which exhibited lower IC50 values on human Hela and HT-29 cell lines, were selected for screening against normal human embryonic kidney (HEK-293) cells. The selectivity index (SI) was calculated using Formula (5):
Our results show only a modest SI value for Aspergillus sp. XJA6 (SI = 9.3, between Hela and HEK-293 cells) compared with known anticancer drugs (Table 6). However A. terreus XJA8 displayed an SI value of 13.8 between HT-29 and HEK-293 cells, warranting further screening.
Table 6.
IC50 values of normal human embryonic kidney (HEK-293) cells and selectivity index (SI) values of antiproliferative crude extracts of Aspergillus sp. XJA6 and A. terreus XJA8.
Some secondary metabolites from V. anthelmintica, in particular the known sesquiterpene lactones, exhibited significant antiproliferative activities against the cancer cell lines A549, Hela and MDA-MB-231, displaying IC50 values up to 1.00 μM [50]. Further studies are needed to identify active natural compounds potentially useful in the discovery of novel cytotoxic drugs.
3.7. DPPH Radical Scavenging Assay
Antioxidant properties of endophytes have been assayed using the DPPH radical scavenging assay. Liu et al. [51] evaluated antioxidant activities and chemical composition of endophytic Xylaria sp. from Ginkgo biloba. Cui et al. [52] investigated the antioxidant activity of secondary metabolites from Aspergillus ochraceus, an endophytic fungus produced by the marine brown alga Sargassum kjellmanianum. These investigations have provided important information in our studies using the DPPH radical scavenging assay. In the current study, the antioxidant capacities of the selected crude extracts of endophytic fungi tested were in 0.005 μg/mL, and concentrations were evaluated by the most commonly used antioxidant assay, DPPH (Table 7). The S. commune XJA1 extract showed moderate antioxidant activity with an IC50 value of 55.21 ± 0.3 μg/mL. Talaromyces sp. XJA4 and A. terreus XJA8 extracts showed low inhibitions of 171.78 ± 8.06 and 215.838 ± 7.25 μg/mL, respectively. Extracts of Aspergillus sp. XJA6 did not display any activity. Crude extracts of Aspergillus also demonstrated no activity.
Table 7.
Antioxidant activity of ethyl acetate crude extract from selected endophytic fungi.
4. Conclusions
In the present study, the biological activities of endophytic fungi isolated from V. anthelmintica, grown in Hotan, People’s Republic of China, are demonstrated. Four fungal isolates were studied: two Aspergillus sp., one from Talaromyces sp. and the fourth from Schizophyllum sp. Ethyl acetate extracts of endophytic fungi exhibited several biological activities, including antimicrobial, cytotoxic, antioxidant, antidiabetic and melanin content, and tyrosinase activity on murine B16 cells. The A. terreus XJA8 and Aspergillus sp. XJA6 showed strong activity in melanin synthesis. Moreover, these strains, such as Aspergillus sp. XJA6 and A. terreus XJA8 strain, showed activity against the following human cancer cell lines: Hela (cervical cancer), HT-29 (colon cancer) with IC50 of 9.99 ± 0.8 μg/mL and 5.73 ± 0.6 μg/mL, respectively. Aspergillus sp. XJA6 showed higher biological activity than the other strains. Twenty-four volatile compounds from the petroleum ether fraction were characterized by GC–MS in our study, but others, particularly those from the ethyl acetate fractions, require further investigation to determine the components with potential in future drug development. Our laboratory is continuing to pursue this research.
Author Contributions
N.R. conducted all experiments, lab work and prepared the manuscript draft. Y.G. analyzed data, Y.Z. identified fungal strains, A.Y. revised the manuscript. All authors have read and agreed to the published version of the manuscript.
Funding
This work was supported by the grants of the National Science and Technology Project “Major New Drug creation-Research and Development of New Drug varieties and its key Innovation Technology” (Project number: 2017ZX09301045), “Tianshan Talent” Program of the Autonomous region in 2017, and the Central Asian Drug Discovery and Development center of the Chinese Academy of Science.
Acknowledgments
The authors thank Ben Prickril and William N. Setzer for corrections and revisions of the manuscript.
Conflicts of Interest
The authors declare no conflicts of interest. The funders had no role in the design of the study; in the collection, analyses, or interpretation of data; in the writing of the manuscript, or in the decision to publish the results.
References
- Asaf, S.; Khan, M.A.; Khan, A.L.; Waqas, M.; Shahzad, R.; Kim, A.-Y.; Kang, S.-M.; Lee, I.-J. Bacterial endophytes from arid land plants regulate endogenous hormone content and promote growth in crop plants: An example of Sphingomonas sp. and Serratia marcescens. J. Plant. Interact. 2017, 12, 31–38. [Google Scholar] [CrossRef]
- Akhter, N.; Pan, C.; Liu, Y.; Shi, Y.; Wu, B. Isolation and structure determination of a new indene derivative from endophytic fungus Aspergillus flavipes Y-62. Nat. Prod. Res. 2019, 33, 2939–2944. [Google Scholar] [CrossRef]
- Khan, A.L.; Waqas, M.; Hussain, J.; Al-Harrasi, A.; Al-Rawahi, A.; Al-Hosni, K.; Kim, M.-J.; Adnan, M.; Lee, I.-J. Endophytes Aspergillus caespitosus LK12 and Phoma sp. LK13 of Moringa peregrina produce gibberellins and improve rice plant growth. J. Plant. Interact. 2014, 9, 731–737. [Google Scholar] [CrossRef]
- Xie, S.; Wu, Y.; Qiao, Y.; Guo, Y.; Wang, J.; Hu, Z.; Zhang, Q.; Li, X.; Huang, J.; Zhou, Q.; et al. Protoilludane, Illudalane, and Botryane Sesquiterpenoids from the Endophytic Fungus Phomopsis sp. TJ507A. J. Nat. Prod. 2018, 81, 1311–1320. [Google Scholar] [CrossRef]
- Liao, G.; Wu, P.; Xue, J.; Liu, L.; Li, H.; Wei, X. Asperimides A–D, anti-inflammatory aromatic butenolides from a tropical endophytic fungus Aspergillus terreus. Fitoterapia 2018, 131, 50–54. [Google Scholar] [CrossRef] [PubMed]
- Cui, H.; Liu, Y.; Li, T.; Zhang, Z.; Ding, M.; Long, Y.; She, Z. 3-Arylisoindolinone and sesquiterpene derivatives from the mangrove endophytic fungi Aspergillus versicolor SYSU-SKS025. Fitoterapia 2018, 124, 177–181. [Google Scholar] [CrossRef] [PubMed]
- Qin, D.; Shen, W.; Wang, J.; Han, M.; Chai, F.; Duan, X.; Yan, X.; Guo, J.; Gao, T.; Zuo, S.; et al. Enhanced production of unusual triterpenoids from Kadsura angustifolia fermented by a symbiont endophytic fungus, Penicillium sp. SWUKD4.1850. Phytochemistry 2019, 158, 56–66. [Google Scholar] [CrossRef] [PubMed]
- Ishiuchi, K.I.; Hirose, D.; Suzuki, T.; Nakayama, W.; Jiang, W.-P.; Monthakantirat, O.; Wu, J.-B.; Kitanaka, S.; Makino, T. Identification of Lycopodium Alkaloids Produced by an Ultraviolet-Irradiated Strain of Paraboeremia, an Endophytic Fungus from Lycopodium serratum var. longipetiolatum. J. Nat. Prod. 2018, 81, 1143–1147. [Google Scholar] [CrossRef] [PubMed]
- Zhang, P.-L.; Wang, G.; Xu, F.-Q.; Liu, J.-S.; Wang, J.-T.; Zhang, R.; Liu, H.-T.; Hu, J.-M.; Wang, G.-K.; Wu, P.-Y. Aspergilolide, a steroid lactone produced by an endophytic fungus Aspergillus sp. MBL1612 isolated from Paeonia ostii. Nat. Prod. Res. 2019, 33, 2133–2138. [Google Scholar] [CrossRef]
- Hu, H.-B.; Luo, Y.-F.; Wang, P.; Wang, W.-J.; Wu, J. Xanthone-derived polyketides from the Thai mangrove endophytic fungus Phomopsis sp. xy21. Fitoterapia 2018, 131, 265–271. [Google Scholar] [CrossRef]
- Numonov, S.; Edirs, S.; Bobakulov, K.; Qureshi, M.N.; Bozorov, K.; Sharopov, F.; Setzer, W.N.; Zhao, H.; Habasi, M.; Sharofova, M.; et al. Evaluation of the Antidiabetic Activity and Chemical Composition of Geranium collinum Root Extracts—Computational and Experimental Investigations. Molecules 2017, 22, 983. [Google Scholar] [CrossRef] [PubMed]
- Kornsakulkarn, J.; Choowong, W.; Rachtawee, P.; Boonyuen, N.; Kongthong, S.; Isaka, M.; Thongpanchang, C. Bioactive hydroanthraquinones from endophytic fungus Nigrospora sp. BCC 47789. Phytochem. Lett. 2018, 24, 46–50. [Google Scholar] [CrossRef]
- Wang, P.; Yu, J.-H.; Zhu, K.; Wang, Y.; Cheng, Z.-Q.; Jiang, C.-S.; Dai, J.-G.; Wu, J.; Zhang, H. Phenolic bisabolane sesquiterpenoids from a Thai mangrove endophytic fungus, Aspergillus sp. xy02. Fitoterapia 2018, 127, 322–327. [Google Scholar] [CrossRef] [PubMed]
- Xiao, W.-J.; Chen, H.-Q.; Wang, H.; Cai, C.-H.; Mei, W.-L.; Dai, H.-F. New secondary metabolites from the endophytic fungus Fusarium sp. HP-2 isolated from “Qi-Nan” agarwood. Fitoterapia 2018, 130, 180–183. [Google Scholar] [CrossRef]
- Padhi, S.; Masi, M.; Panda, S.K.; Luyten, W.; Cimmino, A.; Tayung, K.; Evidente, A. Antimicrobial secondary metabolites of an endolichenic Aspergillus niger isolated from lichen thallus of Parmotrema ravum. Nat. Prod. Res. 2019, 1–8. [Google Scholar] [CrossRef]
- Xin, X.-Q.; Chen, Y.; Zhang, H.; Li, Y.; Yang, M.-H.; Kong, L.-Y. Cytotoxic seco-cytochalasins from an endophytic Aspergillus sp. harbored in Pinellia ternata tubers. Fitoterapia 2019, 132, 53–59. [Google Scholar] [CrossRef]
- Sharma, V.; Singamaneni, V.; Sharma, N.; Kumar, A.; Arora, D.; Kushwaha, M.; Bhushan, S.; Jaglan, S.; Gupta, P. Valproic acid induces three novel cytotoxic secondary metabolites in Diaporthe sp., an endophytic fungus from Datura inoxia Mill. Bioorg. Med. Chem. Lett. 2018, 28, 2217–2221. [Google Scholar] [CrossRef]
- Elissawy, A.M.; Ebada, S.S.; Ashour, M.L.; El-Neketi, M.; Ebrahim, W.; Singab, A.B. New secondary metabolites from the mangrove-derived fungus Aspergillus sp. AV-2. Phytochem. Lett. 2019, 29, 1–5. [Google Scholar] [CrossRef]
- Tian, G.; Zhang, U.; Zhang, T.; Yang, F.; Ito, Y. Separation of flavonoids from the seeds of Vernonia anthelmintica Willd by high-speed counter-current chromatography. J. Chromatogr. A 2004, 1049, 219–222. [Google Scholar] [CrossRef]
- Maimaiti, Z.; Turak, A.; Aisa, H.A. Two new compounds from the seeds of Vernonia anthelmintica. J. Asian Nat. Prod. Res. 2017, 19, 862–868. [Google Scholar] [CrossRef]
- Liu, Y.; Wang, W.-Q.; Chen, T.; Xuan, L.-J. New flavonoid glycosides from seeds of Baccharoides anthelmintica. Nat. Prod. Res. 2020, 34, 284–289. [Google Scholar] [CrossRef] [PubMed]
- Rakhymbay, L.; Turak, A.; Zhenis, Z.; Aisa, H.A. Phenolic Compounds from Vernonia anthelmintica Seeds. Chem. Nat. Compd. 2019, 55, 732–733. [Google Scholar] [CrossRef]
- Rigerte, L.; Blumenstein, K.; Terhonen, E. New R-Based Methodology to Optimize the Identification of Root Endophytes against Heterobasidion parviporum. Microorganisms 2019, 7, 102. [Google Scholar] [CrossRef] [PubMed]
- Santos, I.P.D.; Silva, L.C.N.D.; Silva, M.V.D.; Araújo, J.M.D.; Cavalcanti, M.D.S.; Lima, V.L.D.M. Antibacterial activity of endophytic fungi from leaves of Indigofera suffruticosa Miller (Fabaceae). Front. Micobiol. 2015, 6, 350. [Google Scholar] [CrossRef]
- Li, G.; Kusari, S.; Lamshöft, M.; Schüffler, A.; Laatsch, H.; Spiteller, M. Antibacterial Secondary Metabolites from an Endophytic Fungus, Eupenicillium sp. LG41. J. Nat. Prod. 2014, 77, 2335–2341. [Google Scholar] [CrossRef]
- Rustamova, N.; Wubulikasimu, A.; Mukhamedov, N.; Gao, Y.; Egamberdieva, D.; Yili, A. Endophytic bacteria associated with medicinal plant Vernonia anthelmintica—Diversity and characterization. Curr. Microbiol. 2020. [Google Scholar] [CrossRef]
- Rustamova, N.; Bobakulov, K.; Begmatov, N.; Turak, A.; Yili, A.; Aisa, H.A. Secondary metabolites produced by endophytic Pantoea ananatis derived from roots of Baccharoides anthelmintica and their effect on melanin synthesis in murine B16 cells. Nat. Prod. Res. 2019. [Google Scholar] [CrossRef]
- Nie, L.F.; Bozorov, K.; Niu, C.; Huang, G.; Aisa, H.A. Synthesis and biological evaluation of novel sulfonamide derivatives of tricyclic thieno[2,3-d]pyrimidin-4(3H)-ones on melanin synthesis in murine B16 cells. Res. Chem. Intermed. 2017, 43, 6835–6843. [Google Scholar] [CrossRef]
- Nie, L.F.; Bozorov, K.; Huang, G.; Zhao, J.; Niu, C.; Aisa, H.A. Design, synthesis, and toward a side-ring optimization of tricyclic thieno[2,3-d]pyrimidin-4(3H)-ones and their effect on melanin synthesis in murine B16 cells. Phosphorus Sulfur Silicon Relat. Elem. 2018, 193, 656–667. [Google Scholar] [CrossRef]
- Nie, L.F.; Huang, G.; Bozorov, K.; Zhao, J.; Niu, C.; Sagdullaev, S.S.; Aisa, H.A. Diversity-oriented synthesis of amide derivatives of tricyclic thieno[2,3-d]pyrimidin-4(3H)-ones and evaluation of their influence on melanin synthesis in murine B16 cells. Heterocycl. Commun. 2018, 24, 43–50. [Google Scholar] [CrossRef]
- Niu, C.; Yin, L.; Aisa, H.A. Novel Furocoumarin Derivatives Stimulate Melanogenesis in B16 Melanoma Cells by Up-Regulation of MITF and TYR Family via Akt/GSK3β/β-Catenin Signaling Pathways. Int. J. Mol. Sci. 2018, 19, 746. [Google Scholar] [CrossRef] [PubMed]
- Salamet, E.; Ablajan, T.; Sodik, N.; Xuelei, X.; Akber, A.H. Optimization of Extraction Process for Antidiabetic and Antioxidant Activities of Kursi Wufarikun Ziyabit Using Response Surface Methodology and Quantitative Analysis of Main Components. Evid. Based Complement. Alternat. Med. 2017, 2017, 1–14. [Google Scholar]
- Bozorov, K.; Ma, H.-R.; Zhao, J.-Y.; Zhao, H.-Q.; Chen, H.; Bobakulov, K.; Xin, X.-L.; Elmuradov, B.; Shakhidoyatov, K.; Aisa, H.A. Discovery of diethyl 2,5-diaminothiophene-3,4-dicarboxylate derivatives as potent anticancer and antimicrobial agents and screening of anti-diabetic activity: Synthesis and in vitro biological evaluation. Part 1. Eur. J. Med. Chem. 2014, 84, 739–745. [Google Scholar] [CrossRef] [PubMed]
- Bozorov, K.; Zhao, J.y.; Nie, L.F.; Ma, H.-R.; Bobakulov, K.; Hu, R.; Rustamova, N.; Huang, G.; Efferth, T.; Aisa, H.A. Synthesis and in vitro biological evaluation of novel diaminothiophene scaffolds as antitumor and anti-influenza virus agents. Part 2. RSC Adv. 2017, 7, 31417–31427. [Google Scholar] [CrossRef]
- Bozorov, K.A.; Mamadalieva, N.Z.; Elmuradov, B.Z.; Triggiani, D.; Egamberdieva, D.; Tiezzi, A.; Aisa, H.A.; Shakhidoyatov, K.M. Synthesis of substituted thieno[2,3-D]pyrimidin-4-ones and their testing for evaluation of cytotoxic activity on mammalian cell models. J. Chem. 2013, 1–6. [Google Scholar] [CrossRef]
- Nuerxiati, R.; Abuduwaili, A.; Mutailifu, P.; Wubulikasimu, A.; Rustamova, N.; Jingxue, C.; Aisa, H.A.; Yili, A. Optimization of ultrasonic-assisted extraction, characterization and biological activities of polysaccharides from Orchis chusua D. Don (Salep). Int. J. Biol. Macromol. 2019, 141, 431–443. [Google Scholar] [CrossRef]
- Nishanbaev, S.; Bobakulov, K.; Okhundedaev, B.; Sasmakov, S.; Yusupova, E.; Azimova, S.; Abdullaev, N. Component composition of the extracts and essential oils from the Alhagi canescens, growing in Uzbekistan and their antimicrobial activity. Nat. Prod. Res. 2019, 33, 3417–3420. [Google Scholar] [CrossRef]
- Hua, L.; Li, Y.; Wang, F.; Lu, D.-F.; Gao, K. Biologically active steroids from the aerial parts of Vernonia anthelmintica Willd. Fitoterapia 2012, 83, 1036–1041. [Google Scholar] [CrossRef] [PubMed]
- Rajneesh, R.; Ashok, K.; Vihan, V.S. In vitro antimicrobial property of Vernonia anthelmintica seeds against P. multocida. Indian. Vet. J. 2010, 87, 120–121. [Google Scholar]
- Kamel, R.A.; Abdel-Razek, A.S.; Hamed, A.; Ibrahim, R.R.; Stammler, H.G.; Frese, M.; Sewald, N.; Shaaban, M. Isoshamixanthone: A new pyrano xanthone from endophytic Aspergillus sp. ASCLA and absolute configuration of epiisoshamixanthone. Nat. Prod. Res. 2019, 1–11. [Google Scholar] [CrossRef]
- Turak, A.; Maimaiti, Z.; Ma, H.; Aisa, H.A. Pseudo-disesquiterpenoids from seeds of Vernonia anthelmintica and their biological activities. Phytochem. Lett. 2017, 21, 163–168. [Google Scholar] [CrossRef]
- Gubiani, J.R.; Wijeratne, E.M.K.; Shi, T.; Araujo, A.R.; Arnold, A.E.; Chapman, E.; Gunatilaka, A.A.L. An epigenetic modifier induces production of (10′S)-verruculide B, an inhibitor of protein tyrosine phosphatases by Phoma sp. nov. LG0217, a fungal endophyte of Parkinsonia microphylla. Bioorg. Med. Chem. 2017, 25, 1860–1866. [Google Scholar] [CrossRef] [PubMed]
- Zhang, L.; Li, B.-B.; Li, H.-Z.; Meng, X.; Lin, X.; Jiang, Y.-Y.; Ahn, J.-S.; Cui, L. Four new neolignans isolated from Eleutherococcus senticosus and their protein tyrosine phosphatase 1B inhibitory activity (PTP1B). Fitoterapia 2017, 121, 58–63. [Google Scholar] [CrossRef] [PubMed]
- Lee, D.-S.; Jang, J.-H.; Ko, W.; Kim, K.-S.; Sohn, J.H.; Kang, M.-S.; Ahn, J.S.; Kim, Y.-C.; Oh, H. PTP1B Inhibitory and Anti-Inflammatory Effects of Secondary Metabolites Isolated from the Marine-Derived Fungus Penicillium sp. JF-55. Mar. Drugs 2013, 11, 1409–1426. [Google Scholar] [CrossRef] [PubMed]
- Ai, W.; Wei, X.; Lin, X.; Sheng, L.; Wang, Z.; Tu, Z.; Yang, X.; Zhou, X.; Li, J.; Liu, Y. Guignardins A–F, spirodioxynaphthalenes from the endophytic fungus Guignardia sp. KcF8 as a new class of PTP1B and SIRT1 inhibitors. Tetrahedron 2014, 70, 5806–5814. [Google Scholar] [CrossRef]
- Gao, W.-B.; Han, L.-P.; Xie, F.-X.; Ma, Q.-Y.; Li, X.-F.; Zhang, J.; Zhao, Y.-X.; Luo, D.-Q. A New Polyketide-Derived Metabolite with PTP1B Inhibitory Activity from the Endophytic Fungus Pestalotiopsis neglecta. Chem. Nat. Compd. 2019, 55, 1056–1058. [Google Scholar] [CrossRef]
- Kharwar, R.N.; Mishra, A.; Gond, S.K.; Stierle, A.; Stierle, D. Anticancer compounds derived from fungal endophytes: Their importance and future challenges. Nat. Prod. Rep. 2011, 28, 1208–1228. [Google Scholar] [CrossRef]
- Chen, L.; Zhang, Q.-Y.; Jia, M.; Ming, Q.-L.; Yue, W.; Rahman, K.; Qin, L.-P.; Han, T. Endophytic fungi with antitumor activities: Their occurrence and anticancer compounds. Crit. Rev. Microbiol. 2016, 42, 454–473. [Google Scholar] [CrossRef]
- Chandra, S. Endophytic fungi: Novel sources of anticancer lead molecules. Appl. Microbiol. Biotechnol. 2012, 95, 47–59. [Google Scholar] [CrossRef]
- Ito, T.; Aimaiti, S.; Win, N.N.; Kodama, T.; Morita, H. New sesquiterpene lactones, vernonilides A and B, from the seeds of Vernonia anthelmintica in Uyghur and their antiproliferative activities. Bioorg. Med. Chem. Lett. 2016, 26, 3608–3611. [Google Scholar] [CrossRef]
- Liu, X.; Dong, M.; Chen, X.; Jiang, M.; Lv, X.; Yan, G. Antioxidant activity and phenolics of an endophytic Xylaria sp. from Ginkgo biloba. Food Chem. 2007, 105, 548–554. [Google Scholar] [CrossRef]
- Cui, C.-M.; Li, X.-M.; Li, C.-S.; Sun, H.-F.; Gao, S.-S.; Wang, B.-G. Benzodiazepine Alkaloids from Marine-Derived Endophytic Fungus Aspergillus ochraceus. Helv. Chim. Acta 2009, 92, 1366–1370. [Google Scholar] [CrossRef]
© 2020 by the authors. Licensee MDPI, Basel, Switzerland. This article is an open access article distributed under the terms and conditions of the Creative Commons Attribution (CC BY) license (http://creativecommons.org/licenses/by/4.0/).